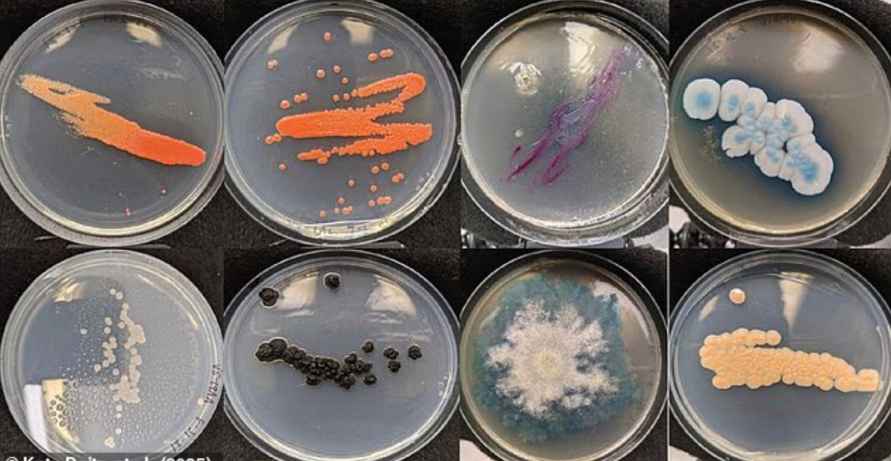
Ученые обнаружили в мундштуках вейпов обильные колонии грибков
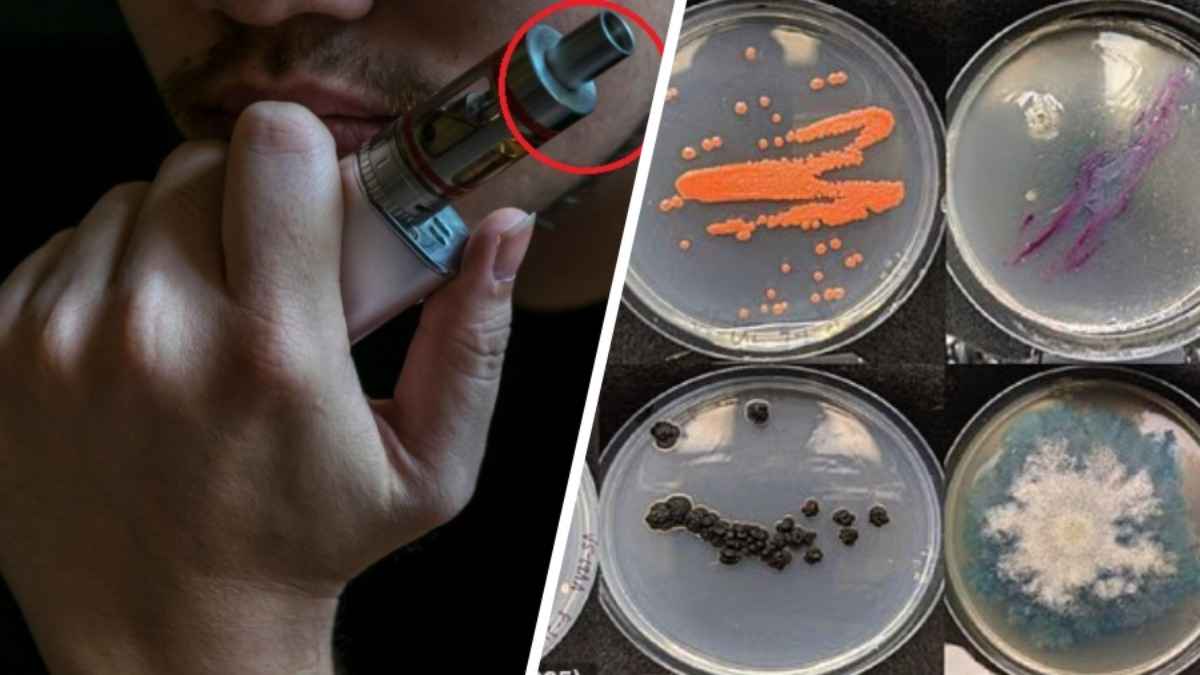
Ученые обнаружили в мундштуках вейпов "обильные колонии" грибков

Ученые обнаружили в мундштуках вейпов "обильные колонии" грибков
Ученые из Университета Флориды (США) обнаружили, что мундштуки для вейпов кишат вредными грибками. По их словам, большая часть способна привести к заболеванию легких.
Как пояснили специалисты, из-за закрытой пластиковой конструкции и частого нагревания при регулярном использовании вейпы представляют собой идеальную среду для развития грибков. Ситуация усугубляется тем фактом, что большинство пользователей заявили, что никогда их не чистят.
Согласно исследованию , более половины протестированных одноразовых вейпов, были «обильно колонизированы» грибками. Из них более 80% способны вызывать проблемы со здоровьем, включая заболевания легких, такие как хронический бронхит.
Наиболее распространенным из этих видов является грибок Cystobasidium minutum, который может вызывать инфекции крови у людей с ослабленной иммунной системой.
Белгоспищепром не поддержал полный запрет на вейпы в Беларуси
Как проводили исследование?
Чтобы исследовать этот вопрос, исследователи набрали 25 участников, которые ежедневно использовали одноразовые вейпы, и взяли мазки с мундштуков их электронных сигарет. Затем ученые культивировали эти образцы, выращивая их в чашках Петри, чтобы увидеть, какие микробы в них скрываются.
В результате выяснилось, что мундштук вейпа кишит до 35 различными видами грибков, подавляющее большинство из которых способны вызывать заболевания.
Образцы также сравнили с культурами, взятыми изо рта участников, что показало, что возбудители инфекций не исходили от самих людей.
Соавтор исследования доктор Джейсон Смит из Института новых патогенов рассказал журналу New Scientist : «Остатки внутри вейп-устройства могут стать источником пищи для роста плесени».
В своей предварительной статье исследователи утверждают, что «грибковое загрязнение электронных сигарет» способствует развитию хронической обструктивной болезни легких (ХОБЛ).
Это заболевание включает в себя группу заболеваний легких, которые вызывают затруднение дыхания, одышку и постоянный кашель с мокротой.
В исследовании треть участников заявили, что у них наблюдались респираторные симптомы, такие как кашель.
Чтобы лучше понять, как вдыхание этих грибков может повлиять на легкие человека, исследователи заставили мышей вдыхать наиболее распространенный патоген — C. minutum.
«Мы обнаружили, что грибок, который был наиболее распространен в образцах вейпа, вызывал признаки хронического бронхита у мышей», — заявил ведущий автор, доктор Борна Мехрад.
Это состояние определяется как воспаление дыхательных путей, которое приводит к симптомам, похожим на грипп, и является одним из состояний, приводящих к ХОБЛ.
Исследователи призвали пользователей вейпов регулярно чистить мундштуки, чтобы избежать скопления грибков. При этом они подчеркнули, что сейчас не проведено достаточно исследований, которые бы показывали, что эти грибки присутствуют в таком количестве, что могут вызвать заболевание у большинства.
Ранее Telegraf.news писал, что в последние годы вейпинг стал популярной альтернативой традиционным сигаретам, привлекая внимание как молодежи, так и взрослых. Однако с ростом его популярности все больше экспертов начали говорить о его влиянии на здоровье. В Евросоюзе уже давно призывают к “жестким мерам” против электронных сигарет. А недавно о их возможном запрете заговорили и в Совете Республики Беларуси. Telegraf.news собрал мнения специалистов Всемирной организации здравоохранения (ВОЗ), США и ЕС, чтобы понять, какие риски могут быть связаны при использовании вейпа и действительно ли “электронки” помогают бросить курить.
Как вейпы влияют на здоровье на самом деле? Собрали, что говорят эксперты ВОЗ, ЕС и США